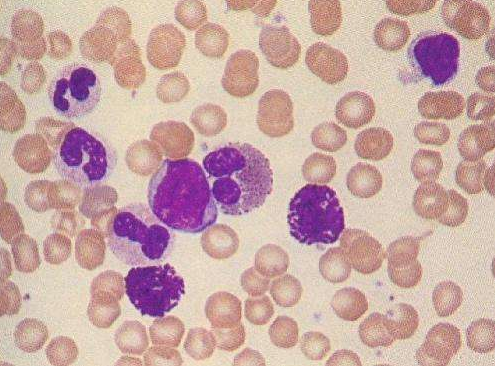
美国治疗白血病

白血病是血液系统恶性肿瘤,也是儿童和青少年多发的恶性肿瘤,在
美国白血病也是多发的,而美国儿童
急性白血病的5年生存率很高,达到了90%以上,美国
治疗白血病的药物也很多,不断研发各种新药,近日,美国FDA已批准Asparlas(长效天冬酰胺特异性酶),作为多药化疗方案的一个组成部分,用于1个月至21岁的儿童和青少年急性淋巴细胞白血病(ALL)患者的治疗。与其他可用的pegaspargase产品相比,Asparlas可提供更长的给药间隔。
Asparlas将为ALL患者群体提供一种新的聚乙二醇化天冬酰胺酶一线治疗药物,同时将提供一种与市面上的聚乙二醇化天冬酰胺酶药物相比具有延长的货架期,这将帮助确保患者对药物的可用性。
Asparlas的开发是基于Oncaspar(培门冬酶)十多年来的数据、研究和临床治疗经验,后者已获美国FDA批准用于ALL的一线治疗。Oncaspar的作用机制被认为是通过水解耗竭血浆中的L-天冬酰胺,来选择性地杀伤白血病细胞。而L-天冬酰胺是某些肿瘤细胞(包括白血病细胞)赖以生存和繁殖的一种必需氨基酸,缺乏L-天冬酰胺会影响蛋白质的合成,较终使肿瘤细胞的生长和增殖受到抑制,从而导致细胞死亡。但正常组织细胞自身具有合成L-天冬酰胺的能力,因此不会受到药物影响。
目前,在临床上,L-天冬酰胺耗竭仍然是众多ALL治疗方案的基石。Asparlas的作用机制也被认为是基于血浆L-天冬酰胺的耗竭。
Asparlas的获批,是基于该药在临床研究中表现出的天冬酰胺酶活性。124例B细胞系ALL患者接受了Asparlas联合多药化疗一线治疗,数据显示,接受每3周一次静脉注射Asparlas 2500U/m2治疗的患者可达到并维持较低血清天冬酰胺酶活性水平高于0.1U/mL。不受威胁性方面,较常见的(发生率≥10%)≥3级不良反应包括转氨酶升高、胆红素升高、胰腺炎和凝血异常。在一项随机研究中,每3周一次静脉注射Asparlas与每2周一次注射Oncaspar(培门冬酶)具有可比的效果和不受威胁性。
ALL是白血细胞的一种癌症,其特征是淋巴母细胞过度生成和积累,这是一种未成熟的白血细胞,通常发现于骨髓中,但ALL患者可在血液和其他部位发现淋巴母细胞。ALL是诊断为白血病的儿童中较常见的类型(约占75%),在某些儿科患者群体中可以得到病愈,在使用包括Oncaspar在内的多药化疗方案治疗的儿童中,5年总生存率为96%。
厚朴方舟2012年进入海外医疗领域,总部位于北京,建立了由全球权威医学专家组成的美日名医集团,初个拥有日本政府官方颁发的海外医疗资格的企业。如果您有海外就医的需要,请拨打免费热线进行咨询!
本文由厚朴方舟编译,版权归厚朴方舟所有,转载或引用本网版权所有之内容须注明"转自厚朴方舟官网(www.hopenoah.com)"字样,对不遵守本声明或其他违法、恶意使用本网内容者,本网保留追究其法律责任的权利。